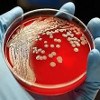

Запись
550₽
+7(383 ..показать +7(499) 11-68-239+7(383) 388-73-24
Клиника XXI век на Некрасова Новосибирск; ул. Некрасова, д. 35 ; м. Сибирская
Запись
550₽
+7(383 ..показать +7(499) 11-68-239+7(383) 388-73-24
Клиника XXI век на Выборной Новосибирск; ул. Выборная, д. 89/2 ; м. Золотая нива
Запись
750₽
+7(495 ..показать +7(499) 11-68-239+7(495) 150-45-85
Доктор Озон на Старокачаловской Москва; ул. Старокачаловская, д. 6 ; м. Бульвар Дмитрия Донского
Запись
750₽
+7(495 ..показать +7(499) 11-68-239+7(495) 741-10-01
А МедКлиник на проспекте Мира Москва; пр-т Мира, д. 102, стр. 23 ; м. Алексеевская
Запись
880₽
+7(499 ..показать +7(499) 11-68-239
MedSwiss на проспекте Обуховской Обороны Санкт-Петербург; пр-т Обуховской Обороны, д. 120Б ; м. Пролетарская
Запись
900₽
+7(937 ..показать +7(499) 11-68-239+7(937) 580-53-05
Профессорская клиника на проспекте Альберта Камалеева Казань; пр-т Альберта Камалеева, д. 8 ; м. Суконная слобода
Запись
1030₽
+7(495 ..показать +7(499) 11-68-239+7(495) 363-03-63 +7(800) 200-36-30
ИНВИТРО на Каширском шоссе Москва; Каширское шоссе, д. 68, корп. 2 ; м. Кантемировская
Запись
1100₽
+7(843 ..показать +7(499) 11-68-239+7(843) 291-00-19
МЦ Звезда на Космонавтов Казань; ул. Космонавтов, д. 16 ; м. Суконная слобода
Запись
1100₽
+7(843 ..показать +7(499) 11-68-239+7(843) 291-00-19
МЦ Звезда на Чистопольской Казань; ул. Чистопольская, д. 38 ; м. Козья слобода
Запись
1150₽
+7(383 ..показать +7(499) 11-68-239+7(383) 201-83-15 +7(913) 930-19-24 +7(983) 001-04-36
Врачебная Практика на Покрышкина Новосибирск; ул. Покрышкина, д. 1 ; м. Площадь Карла Маркса
Запись
1200₽
+7(843 ..показать +7(499) 11-68-239+7(843) 204-02-74 +7(843) 204-04-95
МЦ Качество жизни на Островского Казань; ул. Островского, д. 69/3 ; м. Площадь Габдуллы Тукая
Запись
1200₽
+7(383 ..показать +7(499) 11-68-239+7(383) 312-01-22
Клиника Медпрактика на Красина Новосибирск; ул. Красина, д. 68 ; м. Березовая роща
Запись
1200₽
+7(499 ..показать +7(499) 11-68-239+7(499) 519-35-30 +7(495) 662-58-85
Клиника Семейная на Героев Панфиловцев Москва; ул. Героев Панфиловцев, д. 1 ; м. Сходненская
Запись
1200₽
+7(499 ..показать +7(499) 11-68-239+7(499) 519-35-30 +7(495) 662-58-85
Клиника Семейная на Каширском шоссе Москва; Каширское шоссе, д. 56, корп. 1 ; м. Каширская
Запись
1235₽
+7(843 ..показать +7(499) 11-68-239+7(843) 238-82-84 +7(927) 039-56-29
МЦ Отель-Клиника на Горького Казань; ул. Горького, д. 3А ; м. Кремлёвская
Запись
1270₽
+7(383 ..показать +7(499) 11-68-239+7(383) 349-33-41
Аперто Клиник на Даргомыжского Новосибирск; ул. Даргомыжского, д. 8Г ; м. Заельцовская
Запись
1325₽
+7(343 ..показать +7(499) 11-68-239+7(343) 270-17-17 +7(343) 364-11-25
МЦ Здоровье 365 на Кузнечной Екатеринбург; ул. Кузнечная, д. 83 ; м. Динамо
Запись
1400₽
+7(383 ..показать +7(499) 11-68-239+7(383) 284-08-40
МЦ Эра на проспекте Димитрова Новосибирск; пр-т Димитрова, д. 18 ; м. Площадь Ленина
Запись
2100₽
+7(383 ..показать +7(499) 11-68-239+7(383) 304-84-11 +7(913) 933-96-78 +7(383) 209-04-62
Клиника Диагност в Горском микрорайоне Новосибирск; Горский мкр, д. 8 ; м. Студенческая
Запись
1500₽
+7(499 ..показать +7(499) 11-68-239+7(499) 519-35-30 +7(495) 662-58-85 +7(499) 240-08-10
Клиника Семейная на Брянской Москва; ул. Брянская, д. 3 ; м. Киевская
Ещё клиник - 648 . Используйте фильтры